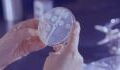
Tuberculosis: This disease from the past could be making a comeback due to COVID

Honestly, who likes mosquitoes anyway? Aside from leaving us with nasty, itchy bites, mosquitoes can also spread diseases like dengue and malaria. So, it's normal to wonder if they could be responsible for further spreading coronavirus. The verdict? No!
Discover our latest podcast
Oral transmission
Rumour has it the black and white tiger mosquito can spread COVID-19 to humans. This couldn't be further from the truth. Mosquitoes bite humans to take their blood and feed their offspring with it. It would, therefore, be necessary for the virus to be transmitted through blood, as is the case with chikungunya, for the mosquito to be a coronavirus carrier.
Scientists all agree that coronavirus is spread through the respiratory tract or by touching contaminated surfaces, not through blood.
How can you protect yourself from tiger mosquitoes?
Although it has been proven that this particular mosquito cannot transmit the coronavirus to us, you should still do what you can do avoid them. How?
- Avoid using scented cosmetics (perfume, scented deodorant, creams, etc.). Sweet smells seem to attract mosquitoes.
- Cover your arms and legs with loose clothing to avoid getting bitten.
- Add fabric softener with mosquito repellent to your laundry loads.
- Use fragrant plants such as lemongrass, geraniums, basil, and lavender to scare them away.
Follow these 4 tips, and you'll be all set to avoid those nasty mosquito bites!